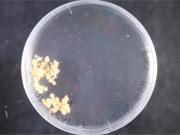

”ザンビアにおける稲作の課題と研究について”Author:Mr. Oscar Malumbe(Zambia Agriculture Research Institute(ZARI))
Oscar Malumbe氏はJICAの留学制度で北海道大学大学院に入学し修士課程を終了しました。現在はプロジェクトの研究分野の主要カウンターパートとして稲作技術の開発を実施しています。今回はOscar氏からザンビアにおける稲作の課題と彼の研究について紹介してもらいます。
近年、ザンビアにおいてコメは重要な主要作物になりつつあります。しかし、コメの国内需要がここ数年増加し続けているのにもかかわらず、コメの国内生産量は需要を満たすのに十分ではありません。ザンビア農業省が発表したCrop Forecast Survey 2020/2021によると、ザンビア国内のコメの生産量は約48,000トンになると予測されていますが、この生産量は年間約70,000トンの国内需要をはるかに下回っています。
国内生産で賄えない分は主にアジアからの輸入によって補われており、第2次国家稲作振興戦略2016-2020によると、国がコメ生産を自給出来ていないことの主な理由として 1)最適な品種が無い 2)不十分な農耕技術 3)不十分な水管理システム 4)機械化への遅れ 5)不十分な人材と組織能力が挙げられます。これらの課題の中で私はZARIの研究者として1)最適な品種が無い、という課題に着目しました。
現在、ザンビアではSUPAと呼ばれる品種が主要品種であり、特徴はアロマを含む食味の良さにあります。これにより消費者からの需要や市場価格も高く、多くの農家がこの品種を好んで栽培します。しかし、SUPAは草丈が高く倒伏しやすいという課題があります。また、ザンビアの雨季で安定した雨量が望めるのは12月から3月の4か月間であり、生育期間が6-7か月(積算温度により異なる)と長く、天水稲作では水不足になるリスクがあります。加えて、6月からは最低気温が15度を切るため、播種が遅れると冷害に合い、収量が安定しないことも課題として挙げられています。
そこで、私は市場に好まれるSUPAの食味を維持したまま、生育期間が短く、倒伏に強い品種を開発したいと考えました。幸いにもJICAの留学制度を活用し、北海道大学で育種の研究をする機会を得られたので、日本の品種とザンビアの在来品種の交雑から上記の形質を持つ新しいイネ品種の開発に取り組みました。品種開発の期間を短縮するために、葯(やく)培養という技術を用いて120系統の倍加半数体の植物体を作ることができました。
北海道大学での留学を終え、ザンビアに戻る際にこの120系統の種子を遺伝資源の移動許可を得て持ち帰り、ZARIで研究を再開しました。
現在はこの120系統の特性評価を行っており、SUPAの栽培課題を克服した新たな品種を選抜し、2023年の品種登録を目指して日々研究しています。
文責 MOReDeP酒井樹里(JICA専門家)

葯の培養から得られた雑種第二世代のカルス培養による植物の開発(北海道大学)。
(A)カルス誘導培地上の葯
葯の培養から得られた雑種第二世代のカルス培養による植物の開発(北海道大学)。
(B)形成されたカルス

葯の培養から得られた雑種第二世代のカルス培養による植物の開発(北海道大学)。
(C)カルスから再生されたアルビノ植物体

葯の培養から得られた雑種第二世代のカルス培養による植物の開発(北海道大学)。
(D)カルスから再生された正常な植物体

葯の培養から得られた雑種第二世代のカルス培養による植物の開発(北海道大学)。
(E)室内で育てられた葯培養由来の植物体

倍化半数体系統の栽培試験の様子(ザンビア、ZARIマンサ試験場)

栽培試験の経過を確認するオスカー氏
